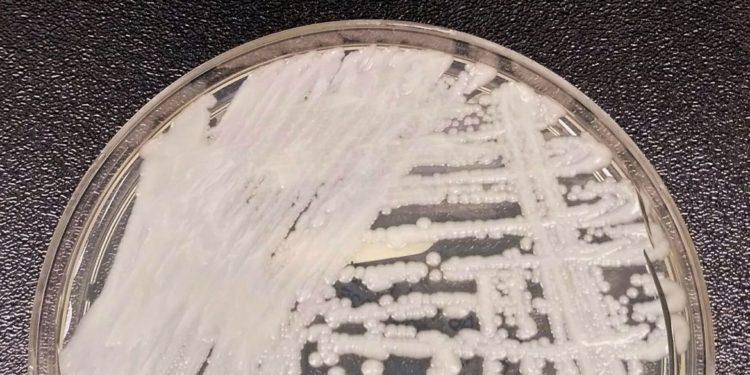
Entenda por que a Candida auris foi apelidada de superfungo

A Agência Nacional de Vigilância Sanitária (Anvisa) confirmou nesta semana o terceiro surto hospitalar de Candida auris no país. Dessa vez, o fungo foi identificado em amostras de urina de dois pacientes que estavam internados num hospital do Recife – um homem de 67 anos e uma mulher de 70 anos.

A levedura – tipo de fungo que possui apenas uma célula – causa grande preocupação nas autoridades sanitárias por ser resistente à maioria dos fungicidas existentes. Em alguns casos, a todos. Isso levou a espécie a receber o apelido de superfungo.
Os organismos do reino Candida são velhos conhecidos da população. Eles causam infecções orais e vaginais bastante comuns nos seres humanos, as candidíases, que são combatidas com fungicidas vendidos em qualquer farmácia.
No caso da Candida auris, porém, as infecções têm se mostrado extremamente difíceis de curar. A espécie produz o que os cientistas chamam de biofilme, camada protetora que a torna resistente ao fluconazol, à anfotericina B e ao equinocandinao, três dos principais compostos antifúngicos.
A espécie é capaz também de infectar o sangue, levando a casos agressivos e muitas vezes letais. Além disso, acomete em geral pacientes graves, que permanecem por longos períodos em unidades intensivas de tratamento. Dos 18 casos identificados até agora no Brasil, dois resultaram em morte.
A Candida auris se demonstrou ainda ser extremamente difícil de controlar, sendo resistente também à maioria dos desinfetantes. “Quando ela chega num hospital, raramente é eliminada”, disse à Agência Brasil o infectologista Flávio Teles, coordenador do Comitê de Micologia da Sociedade Brasileira de Infectologia (SBI).
Não bastasse sua resistência, o patógeno é difícil de identificar, podendo ser confundindo, em laboratórios, com outras espécies de Candida. “Tem essa dificuldade para diagnosticar, porque há um desconhecimento sobre a nova espécie, então acaba podendo passar desapercebido”, frisou o médico infectologista Filipe Prohaska, um dos envolvidos na identificação do surto em Pernambuco.
No Brasil, dois laboratórios estão aptos a identificar a levedura por meio de procedimentos específicos: o Laboratório Especial de Micologia da Escola Paulista de Medicina (Lemi), vinculado à Universidade Federal de São Paulo (Unifespe); e o Laboratório Central de Saúde Pública da Bahia (Lacen-BA).
Histórico
O superfungo foi primeiro identificado no Japão, em 2009, no ouvido de um paciente internado, o que levou ao nome auris – orelha, em latim. Desde então, casos foram reportados em ao menos 47 países, segundo dados compilados pelo Centro de Controle de Doenças dos Estados Unidos (CDC, na sigla em inglês).
Ao todo, foram cerca de 5 mil pessoas infectadas até agora em todo mundo. Foi o suficiente para a Candida auris ser considerada uma das principais ameaças à saúde pública global.
O nível de alerta cresceu bastante durante a pandemia de covid-19, que aumentou em muito o número de internações longas em todo o mundo. “Paciente com covid-19 grave fica muito tempo na UTI, fica tomando corticóide, fica em ventilação mecânica, fatores que são riscos para pacientes adquirirem infecções fúngicas. Tudo isso é um alerta”, disse Teles.
Ainda não é possível saber a origem da Candida auris que apareceu no Brasil. A espécie foi identificada pela primeira vez no cateter de um paciente num hospital de Salvador, em dezembro de 2020. Nesse primeiro surto, 15 pessoas foram infectadas. Uma única outra infecção foi identificada também em Salvador, em dezembro de 2021.
Outra característica que torna a espécie preocupante é sua capacidade de sobreviver por meses em superfícies como macas, móveis e instrumentos. É possível, por exemplo, que indivíduos saudáveis transportem o fungo entre unidades hospitalares sem saber.
A transmissão, contudo, se dá somente pelo contato direto com objetos ou pessoas infectadas, uma das poucas características que favorecem sua contenção. Até hoje, por exemplo, nunca foi identificada nenhuma infecção por Candida auris fora do ambiente hospitalar.
Fonte: Agencia Brasil